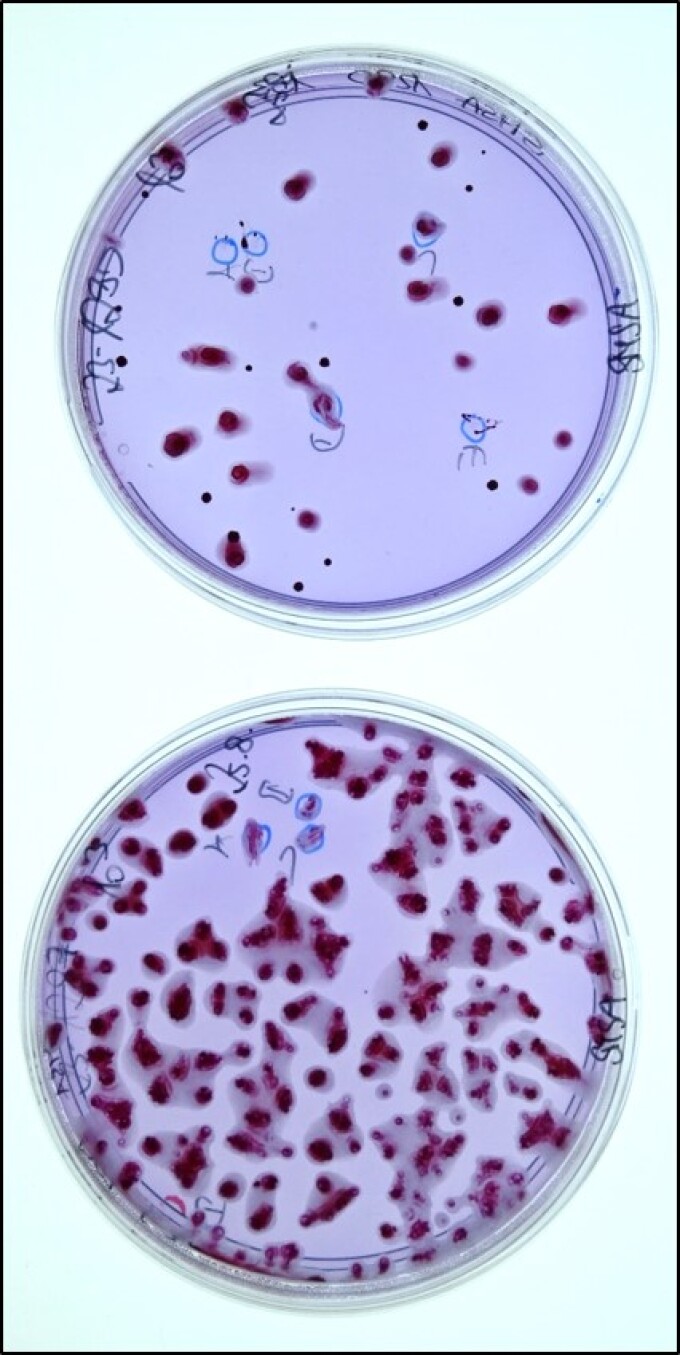
Kolonien mit typischer Morphologie von Ralstonia pseudosolanacearum

Phytopathologische Diagnostik

Ohne eine genaue und differenzierte Untersuchung und Diagnostik ist eine gezielte Einleitung von Maßnahmen gegen Schadorganismen an Pflanzen nicht möglich. Die labordiagnostischen Untersuchungen an Pflanzen und pflanzlichen Erzeugnissen auf biologische Schadursachen, wie Krankheiten und Schädlinge, sind Grundvoraussetzung für einen umweltgerechten Pflanzenschutz und die Durchführung pflanzengesundheitlicher Maßnahmen bei der Einfuhr und dem Verbringen pflanzlicher Sendungen in die Europäische Union beziehungsweise innerhalb der Europäischen Union sowie beim Export.
Ohne eine genaue und differenzierte Untersuchung und Diagnostik ist eine gezielte Einleitung von Maßnahmen gegen Schadorganismen an Pflanzen nicht möglich. Die labordiagnostischen Untersuchungen an Pflanzen und pflanzlichen Erzeugnissen auf biologische Schadursachen, wie Krankheiten und Schädlinge, sind Grundvoraussetzung für einen umweltgerechten Pflanzenschutz und die Durchführung pflanzengesundheitlicher Maßnahmen bei der Einfuhr und dem Verbringen pflanzlicher Sendungen in die Europäische Union beziehungsweise innerhalb der Europäischen Union sowie beim Export.
Akkreditiert durch die Deutsche Akkreditierungsstelle

Phytopathologische Untersuchungen
In der Phytopathologie werden pflanzengesundheitliche Untersuchungen für den amtlichen Pflanzenschutzdienst sowie für die Saatenanerkennungsstelle des Landes Brandenburg durchgeführt. Das beinhaltet Diagnosen von biotischen Schadursachen geschädigter Kulturpflanzen im Rahmen von Monitorings und Schaderregerüberwachungen sowie die Attestierung der Befallsfreiheit bei pflanzlicher Handels- und Vermehrungsware. Die dabei erstellten Befunde dienen als Grundlage des Pflanzenschutzdienstes zur Bewertung der phytosanitären Situation im Land Brandenburg sowie für Beratung und Entscheidungen über Notwendigkeit, Art und Umfang von Pflanzenschutz- und/oder Hygienemaßnahmen.
In der Phytopathologie werden pflanzengesundheitliche Untersuchungen für den amtlichen Pflanzenschutzdienst sowie für die Saatenanerkennungsstelle des Landes Brandenburg durchgeführt. Das beinhaltet Diagnosen von biotischen Schadursachen geschädigter Kulturpflanzen im Rahmen von Monitorings und Schaderregerüberwachungen sowie die Attestierung der Befallsfreiheit bei pflanzlicher Handels- und Vermehrungsware. Die dabei erstellten Befunde dienen als Grundlage des Pflanzenschutzdienstes zur Bewertung der phytosanitären Situation im Land Brandenburg sowie für Beratung und Entscheidungen über Notwendigkeit, Art und Umfang von Pflanzenschutz- und/oder Hygienemaßnahmen.
Übersicht 2023 bis 2025
Im Zeitraum von Januar bis Dezember 2025 wurden insgesamt 46.760 verschiedene Parameter in Einzeluntersuchungen auf Schadorganismen an Pflanzen, Pflanzenteilen, Saatgut oder Bodensubstraten durchgeführt. Dabei lagen auch 2025 die Schwerpunkte der Arbeit bei den Routineuntersuchungen für die Monitorings der Pflanzengesundheitskontrolle und des Gartenbaus, der Schaderregerüberwachung im Ackerbau sowie Gesundheitsuntersuchungen im Rahmen der Saat- und Pflanzgutanerkennung.
Im Zeitraum von Januar bis Dezember 2025 wurden insgesamt 46.760 verschiedene Parameter in Einzeluntersuchungen auf Schadorganismen an Pflanzen, Pflanzenteilen, Saatgut oder Bodensubstraten durchgeführt. Dabei lagen auch 2025 die Schwerpunkte der Arbeit bei den Routineuntersuchungen für die Monitorings der Pflanzengesundheitskontrolle und des Gartenbaus, der Schaderregerüberwachung im Ackerbau sowie Gesundheitsuntersuchungen im Rahmen der Saat- und Pflanzgutanerkennung.
Tabelle U.25.1: Eingesandte Untersuchungsproben im Referat L3 Fachgebiet 2 Phytopathologie, 2023-2025
| Zuordnungen/Fachbereich | Jahr | Bakteriologie | Entomologie | Mykologie | Nematologie | Virologie | Summe |
|---|---|---|---|---|---|---|---|
| Andere Proben | 2023 | 5 | 3 | 1 | 9 | ||
| 2024 | 6 | 7 | 5 | 1 | 4 | 23 | |
| 2025 | 5 | 2 | 7 | ||||
| Kartoffeln | 2023 | 487 | 1 | 36 | 247 | 771 | |
| 2024 | 483 | 1 | 1 | 47 | 46 | 578 | |
| 2025 | 450 | 1 | 1 | 61 | 586 | 1.099 | |
| L2 Ackerbau/Grünland | 2023 | 0 | |||||
| 2024 | 3 | 3 | |||||
| 2025 | 0 | ||||||
| L3 Intern | 2023 | 2 | 11 | 42 | 11 | 3 | 69 |
| 2024 | 1 | 8 | 9 | 6 | 15 | 39 | |
| 2025 | 4 | 6 | 2 | 1 | 11 | 24 | |
| L3 Saatgutanerkennung | 2023 | 6 | 55 | 61 | |||
| 2024 | 1 | 14 | 53 | 1 | 69 | ||
| 2025 | 1 | 10 | 66 | 2 | 79 | ||
| P3 Monitoring | 2023 | 77 | 127 | 228 | 2 | 27 | 461 |
| 2024 | 68 | 91 | 194 | 4 | 69 | 426 | |
| 2025 | 71 | 111 | 184 | 5 | 37 | 408 | |
| P4 Befallsmonitoring | 2023 | 3 | 189 | 24 | 3 | 111 | 330 |
| 2024 | 1 | 22 | 2 | 56 | 81 | ||
| 2025 | 1 | 25 | 12 | 2 | 40 | ||
| P4 EU-Erhebung | 2023 | 31 | 31 | 6 | 8 | 119 | 195 |
| 2024 | 23 | 53 | 32 | 8 | 201 | 317 | |
| 2025 | 22 | 39 | 22 | 3 | 12 | 98 | |
| P4 Export | 2023 | 2 | 30 | 11 | 42 | 85 | |
| 2024 | 10 | 5 | 1 | 4 | 20 | ||
| 2025 | 3 | 10 | 1 | 14 | |||
| P4 Forst | 2023 | 15 | 84 | 99 | |||
| 2024 | 47 | 47 | |||||
| 2025 | 85 | 85 | |||||
| P4 Import | 2023 | 73 | 120 | 34 | 11 | 238 | |
| 2024 | 94 | 34 | 11 | 11 | 150 | ||
| 2025 | 70 | 54 | 48 | 8 | 8 | 188 | |
| P4 Kiefernholznematode | 2023 | 1 | 25 | 26 | |||
| 2024 | 31 | 31 | |||||
| 2025 | 1 | 11 | 12 | ||||
| P4 Unternehmerkontrolle | 2023 | 7 | 7 | 17 | 9 | 32 | 72 |
| 2024 | 3 | 3 | 5 | 70 | 81 | ||
| 2025 | 5 | 1 | 3 | 2 | 9 | 20 | |
| Schaderregerüberwachung | 2023 | 15 | 105 | 99 | 2 | 34 | 255 |
| 2024 | 38 | 117 | 90 | 1 | 74 | 320 | |
| 2025 | 86 | 242 | 98 | 2 | 41 | 469 | |
| Summe | 2023 | 697 | 632 | 535 | 191 | 616 | 2.671 |
| 2024 | 717 | 361 | 410 | 157 | 541 | 2.186 | |
| 2025 | 710 | 498 | 448 | 180 | 707 | 2.543 |
Tabelle U.25.1: Eingesandte Untersuchungsproben im Referat L3 Fachgebiet 2 Phytopathologie, 2023-2025
| Zuordnungen/Fachbereich | Jahr | Bakteriologie | Entomologie | Mykologie | Nematologie | Virologie | Summe |
|---|---|---|---|---|---|---|---|
| Andere Proben | 2023 | 5 | 3 | 1 | 9 | ||
| 2024 | 6 | 7 | 5 | 1 | 4 | 23 | |
| 2025 | 5 | 2 | 7 | ||||
| Kartoffeln | 2023 | 487 | 1 | 36 | 247 | 771 | |
| 2024 | 483 | 1 | 1 | 47 | 46 | 578 | |
| 2025 | 450 | 1 | 1 | 61 | 586 | 1.099 | |
| L2 Ackerbau/Grünland | 2023 | 0 | |||||
| 2024 | 3 | 3 | |||||
| 2025 | 0 | ||||||
| L3 Intern | 2023 | 2 | 11 | 42 | 11 | 3 | 69 |
| 2024 | 1 | 8 | 9 | 6 | 15 | 39 | |
| 2025 | 4 | 6 | 2 | 1 | 11 | 24 | |
| L3 Saatgutanerkennung | 2023 | 6 | 55 | 61 | |||
| 2024 | 1 | 14 | 53 | 1 | 69 | ||
| 2025 | 1 | 10 | 66 | 2 | 79 | ||
| P3 Monitoring | 2023 | 77 | 127 | 228 | 2 | 27 | 461 |
| 2024 | 68 | 91 | 194 | 4 | 69 | 426 | |
| 2025 | 71 | 111 | 184 | 5 | 37 | 408 | |
| P4 Befallsmonitoring | 2023 | 3 | 189 | 24 | 3 | 111 | 330 |
| 2024 | 1 | 22 | 2 | 56 | 81 | ||
| 2025 | 1 | 25 | 12 | 2 | 40 | ||
| P4 EU-Erhebung | 2023 | 31 | 31 | 6 | 8 | 119 | 195 |
| 2024 | 23 | 53 | 32 | 8 | 201 | 317 | |
| 2025 | 22 | 39 | 22 | 3 | 12 | 98 | |
| P4 Export | 2023 | 2 | 30 | 11 | 42 | 85 | |
| 2024 | 10 | 5 | 1 | 4 | 20 | ||
| 2025 | 3 | 10 | 1 | 14 | |||
| P4 Forst | 2023 | 15 | 84 | 99 | |||
| 2024 | 47 | 47 | |||||
| 2025 | 85 | 85 | |||||
| P4 Import | 2023 | 73 | 120 | 34 | 11 | 238 | |
| 2024 | 94 | 34 | 11 | 11 | 150 | ||
| 2025 | 70 | 54 | 48 | 8 | 8 | 188 | |
| P4 Kiefernholznematode | 2023 | 1 | 25 | 26 | |||
| 2024 | 31 | 31 | |||||
| 2025 | 1 | 11 | 12 | ||||
| P4 Unternehmerkontrolle | 2023 | 7 | 7 | 17 | 9 | 32 | 72 |
| 2024 | 3 | 3 | 5 | 70 | 81 | ||
| 2025 | 5 | 1 | 3 | 2 | 9 | 20 | |
| Schaderregerüberwachung | 2023 | 15 | 105 | 99 | 2 | 34 | 255 |
| 2024 | 38 | 117 | 90 | 1 | 74 | 320 | |
| 2025 | 86 | 242 | 98 | 2 | 41 | 469 | |
| Summe | 2023 | 697 | 632 | 535 | 191 | 616 | 2.671 |
| 2024 | 717 | 361 | 410 | 157 | 541 | 2.186 | |
| 2025 | 710 | 498 | 448 | 180 | 707 | 2.543 |
Schaderreger, die besonderen Untersuchungsaufwand verursacht haben, werden im Folgenden dargestellt.
Schaderreger, die besonderen Untersuchungsaufwand verursacht haben, werden im Folgenden dargestellt.
Diplodia sp.
Im Juli und August 2021 wurden in der phytopathologischen Diagnoseeinrichtung des LELF geschädigte Apfelbaumtriebe untersucht. Die Symptomatik an den Trieben kennzeichnete sich durch stark welkende Blütenstände (Abbildung D.21.1). Bei allen Proben wurde im Bereich der welken Blütenstängel und teilweise auf den dazugehörigen Zweigen, ein Befall mit Diplodia seriata beziehungsweise Diplodia sp. mittels Sequenzanalyse und mikroskopischer Untersuchungen nachgewiesen (Abbildung D.21.2). Verschiedene Diplodia Arten sind an Apfelbäumen als Erreger des schwarzen Rindenbrandes bekannt.
Im Juli und Oktober 2021 wurden des weiteren Nadelgehölzproben (Kiefer und Tanne) aus den Gemarkungen Templin, Glindow und Tremmen untersucht, deren Symptome Verbräunungen und das Absterben von Trieben bis hin zum Absterben ganzer Bäumen waren. Auch hier wurde ein massiver Befall der Nadeln (Abbildung D.21.3 - 6), Zapfen und der Zweige mit Schaderregern der Gattung Diplodia sp. mittels mikroskopischer Untersuchung nachgewiesen. Diplodia gilt als primärer Verursacher des Diplodia-Triebsterben an Nadelgehölzen. Es handelt sich aber meist um andere Diplodia-Arten als bei den Obstgehölzen.
Im Juli und August 2021 wurden in der phytopathologischen Diagnoseeinrichtung des LELF geschädigte Apfelbaumtriebe untersucht. Die Symptomatik an den Trieben kennzeichnete sich durch stark welkende Blütenstände (Abbildung D.21.1). Bei allen Proben wurde im Bereich der welken Blütenstängel und teilweise auf den dazugehörigen Zweigen, ein Befall mit Diplodia seriata beziehungsweise Diplodia sp. mittels Sequenzanalyse und mikroskopischer Untersuchungen nachgewiesen (Abbildung D.21.2). Verschiedene Diplodia Arten sind an Apfelbäumen als Erreger des schwarzen Rindenbrandes bekannt.
Im Juli und Oktober 2021 wurden des weiteren Nadelgehölzproben (Kiefer und Tanne) aus den Gemarkungen Templin, Glindow und Tremmen untersucht, deren Symptome Verbräunungen und das Absterben von Trieben bis hin zum Absterben ganzer Bäumen waren. Auch hier wurde ein massiver Befall der Nadeln (Abbildung D.21.3 - 6), Zapfen und der Zweige mit Schaderregern der Gattung Diplodia sp. mittels mikroskopischer Untersuchung nachgewiesen. Diplodia gilt als primärer Verursacher des Diplodia-Triebsterben an Nadelgehölzen. Es handelt sich aber meist um andere Diplodia-Arten als bei den Obstgehölzen.
Popilia japonica
Im Jahr 2021 wurde der Japankäfer Popillia japonica (Abbildung P.21.1 B), ein Quarantäneschädling, erstmals in Deutschland in Baden-Württemberg nachgewiesen. Die erwachsenen Tiere, wie auch die Larven im Boden, können Pflanzen durch ihre Fraßtätigkeit schädigen. Zum etwa 300 Pflanzenarten umfassenden Wirtspflanzenspektrum gehören neben Gehölzen, wie Ahorn, Buche und Eiche, auch landwirtschaftliche und gartenbauliche Kulturen wie Mais, Kartoffeln, Spargel, Tomate, Bohnen, Apfel, Steinobst, Brom- und Himbeere, Erdbeere und Heidelbeere, Weinreben sowie eine Vielzahl an Zierpflanzen. Auch auf Wiesen und Weiden kann es durch Wurzelfraß der Larven zu Schäden kommen. Erwachsene Japankäfer sind etwa 1 cm lang und besitzen einen auffällig goldgrün schimmernden Halsschild. Sie ähneln dem heimischen Gartenlaubkäfer Phyllopertha horticola (Abbildung P.21.1 A), besitzen jedoch im Gegensatz zu diesem 5 weiße Haarbüschel an den Seiten des Hinterleibs, sowie 2 Büschel am letzten Körpersegment (Abbildung P.21.2). Zudem zeigt er ein artcharakteristisches Alarmverhal-ten, indem er bei Gefahr zwei Beine seitlich abspreizt.
Im Jahr 2021 wurde der Japankäfer Popillia japonica (Abbildung P.21.1 B), ein Quarantäneschädling, erstmals in Deutschland in Baden-Württemberg nachgewiesen. Die erwachsenen Tiere, wie auch die Larven im Boden, können Pflanzen durch ihre Fraßtätigkeit schädigen. Zum etwa 300 Pflanzenarten umfassenden Wirtspflanzenspektrum gehören neben Gehölzen, wie Ahorn, Buche und Eiche, auch landwirtschaftliche und gartenbauliche Kulturen wie Mais, Kartoffeln, Spargel, Tomate, Bohnen, Apfel, Steinobst, Brom- und Himbeere, Erdbeere und Heidelbeere, Weinreben sowie eine Vielzahl an Zierpflanzen. Auch auf Wiesen und Weiden kann es durch Wurzelfraß der Larven zu Schäden kommen. Erwachsene Japankäfer sind etwa 1 cm lang und besitzen einen auffällig goldgrün schimmernden Halsschild. Sie ähneln dem heimischen Gartenlaubkäfer Phyllopertha horticola (Abbildung P.21.1 A), besitzen jedoch im Gegensatz zu diesem 5 weiße Haarbüschel an den Seiten des Hinterleibs, sowie 2 Büschel am letzten Körpersegment (Abbildung P.21.2). Zudem zeigt er ein artcharakteristisches Alarmverhal-ten, indem er bei Gefahr zwei Beine seitlich abspreizt.
Querciphoma minuta
Erstnachweis von Querciphoma minuta als Verursacher von Ast- und Stammnekrosen an Platanus x hispanica in Deutschland
Im Rahmen eines Schaderregermonitorings an Platanen durch die Pflanzengesundheitskontrolle des Landesamtes für Ländliche Entwicklung, Landwirtschaft und Flurneuordnung (LELF) im Juli und August 2022 wurden entlang einer Allee in Cottbus Stämme und Äste von 20 Jahre alten Platanen mit großen, dunkelbraunen bis rotbraunen Nekrosen beobachtet wie in Abbildung 1 A-C dargestellt. Untersuchungen im phytopathologischen Diagnoselabor des LELF zeigten, dass sich die Schädigungen von der Rinde bis ins Kernholz erstreckten, was in Abbildung 1 D-E ersichtlich ist. Mittels mikro- und molekularbiologischer Untersuchungen an fünf symptomatischen Ästen von vier ausgewählten Bäumen wurde Querciphoma minuta (Syn. Q. carteri) aus allen untersuchten Proben isoliert und identifiziert. Das zeigt die Abbildung 2. Ein Pathogenitätstest zur Erfüllung der Koch´schen Postulate mit 20 Platanen-Jungpflanzen bestätigte den eindeutigen Zusammenhang zwischen dem Auftreten der beschriebenen Symptome und dem Befall mit Querciphoma minuta (Boldt-Burisch und Douanla-Meli, 2023). Es handelt sich hierbei um den Erstnachweis von Querciphoma minuta als potentiellen Schaderreger an Platanen. Das deutet darauf hin, dass das Wirtsspektrum und Schadpotential dieses Pilzes deutlich größer sein könnte als bisher vermutet.
Erstnachweis von Querciphoma minuta als Verursacher von Ast- und Stammnekrosen an Platanus x hispanica in Deutschland
Im Rahmen eines Schaderregermonitorings an Platanen durch die Pflanzengesundheitskontrolle des Landesamtes für Ländliche Entwicklung, Landwirtschaft und Flurneuordnung (LELF) im Juli und August 2022 wurden entlang einer Allee in Cottbus Stämme und Äste von 20 Jahre alten Platanen mit großen, dunkelbraunen bis rotbraunen Nekrosen beobachtet wie in Abbildung 1 A-C dargestellt. Untersuchungen im phytopathologischen Diagnoselabor des LELF zeigten, dass sich die Schädigungen von der Rinde bis ins Kernholz erstreckten, was in Abbildung 1 D-E ersichtlich ist. Mittels mikro- und molekularbiologischer Untersuchungen an fünf symptomatischen Ästen von vier ausgewählten Bäumen wurde Querciphoma minuta (Syn. Q. carteri) aus allen untersuchten Proben isoliert und identifiziert. Das zeigt die Abbildung 2. Ein Pathogenitätstest zur Erfüllung der Koch´schen Postulate mit 20 Platanen-Jungpflanzen bestätigte den eindeutigen Zusammenhang zwischen dem Auftreten der beschriebenen Symptome und dem Befall mit Querciphoma minuta (Boldt-Burisch und Douanla-Meli, 2023). Es handelt sich hierbei um den Erstnachweis von Querciphoma minuta als potentiellen Schaderreger an Platanen. Das deutet darauf hin, dass das Wirtsspektrum und Schadpotential dieses Pilzes deutlich größer sein könnte als bisher vermutet.
Abbildung 1: (A) Stammnekrose (Foto: M. Schemmel, LELF) und (B-C) Astnekrosen mit äußerlichen Symptomen und (D-E) innerliche Verbräunungen bis ins Kernholz gehend an Platanen im Juli und August 2022 in Cottbus (Fotos B-E: K. Boldt-Burisch, LELF)
Abbildung 1: (A) Stammnekrose (Foto: M. Schemmel, LELF) und (B-C) Astnekrosen mit äußerlichen Symptomen und (D-E) innerliche Verbräunungen bis ins Kernholz gehend an Platanen im Juli und August 2022 in Cottbus (Fotos B-E: K. Boldt-Burisch, LELF)
Abbildung 2: Querciphoma minuta (A) Conidiomata auf synthetischem nährstoffarmen Agar und (B) Conidiomata mit Setae und Koninien
Abbildung 2: Querciphoma minuta (A) Conidiomata auf synthetischem nährstoffarmen Agar und (B) Conidiomata mit Setae und Koninien
Literatur
Boldt-Burisch, K.; Douanla-Meli, C., 2023: First report of Querciphoma minuta causing branch and stem canker in Platanus × hispanica in Germany. New Disease Reports 47, e12153. https://doi.org/10.1002/ndr2.12153
Literatur
Boldt-Burisch, K.; Douanla-Meli, C., 2023: First report of Querciphoma minuta causing branch and stem canker in Platanus × hispanica in Germany. New Disease Reports 47, e12153. https://doi.org/10.1002/ndr2.12153
Ralstonia pseudosolanacearum
Nachweis von Ralstonia pseudosolanacearum an Importware
Aufgrund verschiedener Indizien werden Zufuhren von Ingwer und Kurkuma seit August 2023 in Deutschland genauer phytopathologisch untersucht. Ein Grund dafür ist, dass in den letzten Jahren das Bakterium Ralstonia pseudosolanacearum in Verkaufsware und auch im gartenbaulichen Anbau dieser Pflanzenarten nachgewiesen wurde. Ralstonia pseudosolanacearum ist ein gefährliches Bakterium, das bei wichtigen einheimischen Kulturpflanzen wie Kartoffeln und Tomaten zu erheblichen Schäden führen kann. Eine direkte Bekämpfung ist nicht möglich. Betroffene Pflanzen müssen meist vernichtet werden.
In Brandenburg stehen vor allem Importe von Ingwer und Kurkuma am Flughafen BER im Fokus. Seitdem werden wöchentlich meist mehrere Proben davon auf das Vorhandensein von Ralstonia pseudosolanacearum untersucht. In der zweiten Jahreshälfte 2023 wurde dabei fast wöchentlich ein positiver Fund verzeichnet. Das aufwändige Untersuchungsverfahren ist in der Durchführungsverordnung (EU) 2022/1193 genau geregelt. Als Screeningtest wird am LELF eine Real-Time-PCR durchgeführt. Bei positiven Screening-Befunden wird anschließend das Bakterium mikrobiologisch auf Nährboden isoliert. Kolonien mit typischer Morphologie werden selektiert und mittels einer zweiten PCR identifiziert. Erst wenn der zweite PCR Test positiv ist, gilt der Nachweis der Infektion als erbracht. Infizierte Ware darf nicht in den Umlauf gebracht werden.
Nachweis von Ralstonia pseudosolanacearum an Importware
Aufgrund verschiedener Indizien werden Zufuhren von Ingwer und Kurkuma seit August 2023 in Deutschland genauer phytopathologisch untersucht. Ein Grund dafür ist, dass in den letzten Jahren das Bakterium Ralstonia pseudosolanacearum in Verkaufsware und auch im gartenbaulichen Anbau dieser Pflanzenarten nachgewiesen wurde. Ralstonia pseudosolanacearum ist ein gefährliches Bakterium, das bei wichtigen einheimischen Kulturpflanzen wie Kartoffeln und Tomaten zu erheblichen Schäden führen kann. Eine direkte Bekämpfung ist nicht möglich. Betroffene Pflanzen müssen meist vernichtet werden.
In Brandenburg stehen vor allem Importe von Ingwer und Kurkuma am Flughafen BER im Fokus. Seitdem werden wöchentlich meist mehrere Proben davon auf das Vorhandensein von Ralstonia pseudosolanacearum untersucht. In der zweiten Jahreshälfte 2023 wurde dabei fast wöchentlich ein positiver Fund verzeichnet. Das aufwändige Untersuchungsverfahren ist in der Durchführungsverordnung (EU) 2022/1193 genau geregelt. Als Screeningtest wird am LELF eine Real-Time-PCR durchgeführt. Bei positiven Screening-Befunden wird anschließend das Bakterium mikrobiologisch auf Nährboden isoliert. Kolonien mit typischer Morphologie werden selektiert und mittels einer zweiten PCR identifiziert. Erst wenn der zweite PCR Test positiv ist, gilt der Nachweis der Infektion als erbracht. Infizierte Ware darf nicht in den Umlauf gebracht werden.
Moroccan watermelon mosaic virus – ein Erstbefund in Brandenburg
2024 wurde das bisher in Brandenburg unbekannte Potyvirus Moroccan watermelon mosac virus (MWMV; Potyvirus citrullimoroccense) erstmalig nachgewiesen. Auffällige Kürbis- und Zucchinipflanzen wurden vom Pflanzenschutzdienst in zwei Gartenbaubetrieben beprobt und in dem phytopathologischen Labor des LELF, mittels der RT-PCR in Zusammenarbeit mit dem Julius-Kühn-Institut, untersucht und MWMV wurde identifiziert. Befallene Pflanzen zeigten Blattvergilbungen (Chlorosen) und Blattverformungen, gelbe Flecken und Ringflecken auf den Früchten sowie eine Wuchshemmung und Ertragsminderung der Zucchinipflanzen (siehe Abbildungen 1 und 2). In einer der Proben konnte zusätzlich eine Doppelinfektion mit einem zweiten Potyvirus, das Zucchini yellow mosaik virus (ZYMV; Potyvirus cucurbitaflavitesselati), nachgewiesen werden. Potyviren bilden eine der größten Gruppen der Pflanzenviren und zu den Wirtspflanzen gehören viele ökonomisch wichtige Kulturpflanzen, zum Beispiel Kartoffeln und Pflaumen. MWMV wurde zuerst in Marokko in den 1970er Jahren beschrieben und hat sich seitdem in Afrika und im Mittelmeergebiet ausgebreitet. Zu den Wirtspflanzen des Virus gehören Kürbisgewächse und Papaya, bei denen das Virus erhebliche Ertragsverluste verursachen kann. Der Krankheitserreger wurde schon unter anderem in Spanien, Frankreich und Italien gefunden und ist daher in der EU nicht geregelt. MWMV wird durch Blattläuse, beispielsweise die Grüne Pfirsichblattlaus (Myzus persicae), übertragen aber weitere Übertragungswege, wie zum Beispiel durch das Saatgut, sind nicht auszuschließen. Wie das Virus in Brandenburg eingeschleppt wurde, sowie ein Zusammenhang zwischen den beiden Fundorten, die circa 80 km auseinanderliegen, war nicht festzustellen. Das Auftreten von symptomatischen Pflanzen wird in der neuen Saison beobachtet.
2024 wurde das bisher in Brandenburg unbekannte Potyvirus Moroccan watermelon mosac virus (MWMV; Potyvirus citrullimoroccense) erstmalig nachgewiesen. Auffällige Kürbis- und Zucchinipflanzen wurden vom Pflanzenschutzdienst in zwei Gartenbaubetrieben beprobt und in dem phytopathologischen Labor des LELF, mittels der RT-PCR in Zusammenarbeit mit dem Julius-Kühn-Institut, untersucht und MWMV wurde identifiziert. Befallene Pflanzen zeigten Blattvergilbungen (Chlorosen) und Blattverformungen, gelbe Flecken und Ringflecken auf den Früchten sowie eine Wuchshemmung und Ertragsminderung der Zucchinipflanzen (siehe Abbildungen 1 und 2). In einer der Proben konnte zusätzlich eine Doppelinfektion mit einem zweiten Potyvirus, das Zucchini yellow mosaik virus (ZYMV; Potyvirus cucurbitaflavitesselati), nachgewiesen werden. Potyviren bilden eine der größten Gruppen der Pflanzenviren und zu den Wirtspflanzen gehören viele ökonomisch wichtige Kulturpflanzen, zum Beispiel Kartoffeln und Pflaumen. MWMV wurde zuerst in Marokko in den 1970er Jahren beschrieben und hat sich seitdem in Afrika und im Mittelmeergebiet ausgebreitet. Zu den Wirtspflanzen des Virus gehören Kürbisgewächse und Papaya, bei denen das Virus erhebliche Ertragsverluste verursachen kann. Der Krankheitserreger wurde schon unter anderem in Spanien, Frankreich und Italien gefunden und ist daher in der EU nicht geregelt. MWMV wird durch Blattläuse, beispielsweise die Grüne Pfirsichblattlaus (Myzus persicae), übertragen aber weitere Übertragungswege, wie zum Beispiel durch das Saatgut, sind nicht auszuschließen. Wie das Virus in Brandenburg eingeschleppt wurde, sowie ein Zusammenhang zwischen den beiden Fundorten, die circa 80 km auseinanderliegen, war nicht festzustellen. Das Auftreten von symptomatischen Pflanzen wird in der neuen Saison beobachtet.
Übersicht 2025
Arbeitsschwerpunkte lagen wie in den Vorjahren bei geplanten Serienuntersuchungen von Kartoffeln, Bodenproben, Tomaten und Zierpflanzen auf rechtlich geregelte Schaderreger wie Clavibacter sepedonicus, Ralstonia solanacearum, Globodera pallida, Globodera rostochiensis, Tomato Brown Rugose Fruit Virus beziehungsweise Xylella fastidiosa. Hervorzuheben sind besonders aufwendige Untersuchungen an Importen von Kukurma und Ingwer. Die am BER zugeführte Ware stammt aus Südostasien und ist auf das Vorhandensein des rechtlich geregelten Bakteriums Ralstonia pseudosolanacearum zu untersuchen. 2025 wurde dieser Erreger aber weniger häufig als im Vorjahr in dem Proben nachgewiesen. Ein weiterer Schwerpunkt lag bei der Untersuchung der Schilf-Glasflügelzikade Pentastiridius leporinus und der beiden von ihr übertragenen bakteriellen Schaderreger Stolbur Phytoplasma und Candidatus Arsenophonus phytopathogenicus. Extra für diesen Schaderregerkomplex wurden neue Verfahrensabläufe und Untersuchungsverfahren eingeführt.
Neben den Serienuntersuchungen stellen Einzeluntersuchungen insbesondere tierischer und pilzlicher Schaderreger einen erheblichen Arbeitsaufwand dar. Rein von der Probenanzahl gehören diese Arbeiten scheinbar nicht zu den Schwerpunkten. Aber aufgrund der Schwierigkeit spezieller taxonomischer Bestimmungen, meist auch unter Einbeziehung molekularer Techniken wie der Sequenzanalyse und/oder der hohen Anzahl von Teil- und Einzeluntersuchungen, sind diese Proben eine große fachliche und zeitliche Herausforderung für die Sachbearbeiter. Denn meist muss eine Probe auf verschiedene Schaderreger (Parameter) gleichzeitig untersucht werden.
Arbeitsschwerpunkte lagen wie in den Vorjahren bei geplanten Serienuntersuchungen von Kartoffeln, Bodenproben, Tomaten und Zierpflanzen auf rechtlich geregelte Schaderreger wie Clavibacter sepedonicus, Ralstonia solanacearum, Globodera pallida, Globodera rostochiensis, Tomato Brown Rugose Fruit Virus beziehungsweise Xylella fastidiosa. Hervorzuheben sind besonders aufwendige Untersuchungen an Importen von Kukurma und Ingwer. Die am BER zugeführte Ware stammt aus Südostasien und ist auf das Vorhandensein des rechtlich geregelten Bakteriums Ralstonia pseudosolanacearum zu untersuchen. 2025 wurde dieser Erreger aber weniger häufig als im Vorjahr in dem Proben nachgewiesen. Ein weiterer Schwerpunkt lag bei der Untersuchung der Schilf-Glasflügelzikade Pentastiridius leporinus und der beiden von ihr übertragenen bakteriellen Schaderreger Stolbur Phytoplasma und Candidatus Arsenophonus phytopathogenicus. Extra für diesen Schaderregerkomplex wurden neue Verfahrensabläufe und Untersuchungsverfahren eingeführt.
Neben den Serienuntersuchungen stellen Einzeluntersuchungen insbesondere tierischer und pilzlicher Schaderreger einen erheblichen Arbeitsaufwand dar. Rein von der Probenanzahl gehören diese Arbeiten scheinbar nicht zu den Schwerpunkten. Aber aufgrund der Schwierigkeit spezieller taxonomischer Bestimmungen, meist auch unter Einbeziehung molekularer Techniken wie der Sequenzanalyse und/oder der hohen Anzahl von Teil- und Einzeluntersuchungen, sind diese Proben eine große fachliche und zeitliche Herausforderung für die Sachbearbeiter. Denn meist muss eine Probe auf verschiedene Schaderreger (Parameter) gleichzeitig untersucht werden.
Tabelle U.25.2: Einzeluntersuchungen in der Phytopathologie, 2025
| Fachbereich/-gebiet | Bakteriologie | Entomologie | Mykologie | Nematologie | Virologie | Summe |
|---|---|---|---|---|---|---|
| Andere Proben | 5 | 2 | 7 | |||
| Kartoffeln | 2.700 | 1 | 1 | 5.084 | 10.417 | 18.203 |
| L2 Ackerbau/Grünland | 0 | |||||
| L3 Intern | 4 | 6 | 2 | 1 | 11 | 24 |
| L3 Saatgutanerkennung | 1 | 10 | 26.400 | 25.413 | ||
| P3 Monitoring | 71 | 111 | 184 | 5 | 37 | 408 |
| P4 Befallsmonitoring | 1 | 25 | 12 | 2 | 40 | |
| P4 EU-Erhebung | 44 | 39 | 22 | 3 | 72 | 180 |
| P4 Export | 3 | 10 | 1 | 14 | ||
| P4 Forst | 170 | 170 | ||||
| P4 Import | 280 | 54 | 48 | 8 | 8 | 398 |
| P4 Kiefernholznematode | 1 | 44 | 45 | |||
| P4 Unternehmerkontrolle | 5 | 1 | 3 | 2 | 9 | 20 |
| Schaderregerüberwachung | 86 | 242 | 98 | 2 | 410 | 838 |
| Summe | 3.192 | 498 | 26.782 | 5.321 | 10.967 | 46.760 |
Tabelle U.25.2: Einzeluntersuchungen in der Phytopathologie, 2025
| Fachbereich/-gebiet | Bakteriologie | Entomologie | Mykologie | Nematologie | Virologie | Summe |
|---|---|---|---|---|---|---|
| Andere Proben | 5 | 2 | 7 | |||
| Kartoffeln | 2.700 | 1 | 1 | 5.084 | 10.417 | 18.203 |
| L2 Ackerbau/Grünland | 0 | |||||
| L3 Intern | 4 | 6 | 2 | 1 | 11 | 24 |
| L3 Saatgutanerkennung | 1 | 10 | 26.400 | 25.413 | ||
| P3 Monitoring | 71 | 111 | 184 | 5 | 37 | 408 |
| P4 Befallsmonitoring | 1 | 25 | 12 | 2 | 40 | |
| P4 EU-Erhebung | 44 | 39 | 22 | 3 | 72 | 180 |
| P4 Export | 3 | 10 | 1 | 14 | ||
| P4 Forst | 170 | 170 | ||||
| P4 Import | 280 | 54 | 48 | 8 | 8 | 398 |
| P4 Kiefernholznematode | 1 | 44 | 45 | |||
| P4 Unternehmerkontrolle | 5 | 1 | 3 | 2 | 9 | 20 |
| Schaderregerüberwachung | 86 | 242 | 98 | 2 | 410 | 838 |
| Summe | 3.192 | 498 | 26.782 | 5.321 | 10.967 | 46.760 |
Abbildung U.25.3: Aufteilung untersuchter Parameter auf die Fachgebiete 2025 in Prozent

Abbildung U.25.3: Aufteilung untersuchter Parameter auf die Fachgebiete 2025 in Prozent
Abbildung U.25.4: Probenzahlen Phytopathologie 2025 in Prozent

Abbildung U.25.4: Probenzahlen Phytopathologie 2025 in Prozent